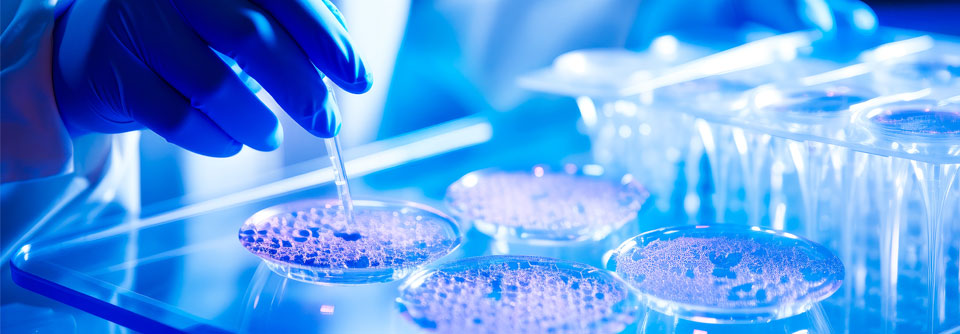

Neutropenie-Diät Keine erhöhten Infektionsraten mit weniger eingeschränkter Kost nach Stammzelltransplantation
 Eine Studie liefert den Gegenbeweis, dass eine restriktive Ernährung nach autologer oder allogener Stammzelltransplantation das Infektionsrisiko in der Neutropenie nicht senkt.
© ronstik – stock.adobe.com
Eine Studie liefert den Gegenbeweis, dass eine restriktive Ernährung nach autologer oder allogener Stammzelltransplantation das Infektionsrisiko in der Neutropenie nicht senkt.
© ronstik – stock.adobe.com
Wir wollen sinnlose Interventionen vermeiden“, betonte Dr. Federico Stella von der Universitätsklinik in Mailand.1 Dazu gehört nach den von ihm vorgestellten Studienergebnissen eine restriktive Neutropenie-Diät, in deren Rahmen rohe Gemüse und Früchte, Aufschnitt und Wurstwaren, Joghurt, Honig sowie roher Fisch und rohes Fleisch verboten sind. Erlaubt werden nur Lebensmittel, die bei über 80 °C gekocht wurden und/oder geschältes dickschaliges Obst. Eine multizentrische, randomisiert-kontrollierte Studie zur Sinnhaftigkeit einer solchen Diät wurde jetzt in Italien durchgeführt: „Essen ist Teil der Lebensqualität, in Italien sowieso, aber auch in anderen europäischen Ländern.“
Eingeschlossen wurden 222 erwachsene Personen, die sich einer autologen oder allogenen Stammzelltransplantation unterzogen und eine Hochdosis-Chemotherapie erhielten, die mit einer Neutropenie länger als sieben Tage einherging. Die Teilnehmenden folgten entweder der beschriebenen protektiven Diät (n = 111) oder sie bekamen eine gering eingeschränkte Ernährung – eine normale Krankenhauskost, bei der nur rohes Fleisch oder roher Fisch verboten waren (n = 111).
Vom Standard abzuweichen, ist schwer
Leicht ist es nicht, von der „protektiven“ Diät zu lassen, berichtete Prof. Dr. Mikkael Sekeres, Universitätsklinik in Miami, in einer Pressekonferenz.2 Er erlebte starke Widerstände bei der Einführung einer wenig eingeschränkten Ernährung nach Stammzelltransplantation an seiner Klinik. „Es ist eben eine ewig lange Tradition und klingt ja auch so logisch.“
Quelle:
Sekeres M. 64th ASH Annual Meeting; Session: Treating Blood Cancers: Changing the Status Quo
Eine unnötige Belastung
Die Studie sollte die Nichtunterlegenheit der zweiten Gruppe zeigen. Tatsächlich gelang das in allen Endpunkten: So waren die Infektionsraten (≥ Grad 2) nicht signifikant unterschiedlich; sie betrugen mit der restriktiven Diät 65 % und mit der kaum eingeschränkten 62 %. Sowohl gastrointestinale als auch systemische Infektionen traten laut Dr. Stella ähnlich häufig auf, ebenso wie Fieber unklarer Genese. Das Körpergewicht verringerte sich im ersten Monat unter der nicht restriktiven Kost in einem geringeren Ausmaß. Andere Ernährungsparameter wie Serumalbumin oder Body-Mass-Index bis zur Entlassung waren ähnlich. Auch die Inzidenz einer akuten Graft-versus-Host-Disease unterschied sich nicht signifikant, war aber numerisch mit der nicht eingeschränkten Ernährung etwas seltener. Der einzige signifikante Unterschied war die bessere Lebensqualität: 35 % der Patient:innen, die eine kaum restriktive Krankenhauskost bekommen hatten, fühlten sich in ihrer Ernährung nicht eingeschränkt, im anderen Arm galt das nur für 16 % (p = 0,006).
Eine restriktive Ernährung nach autologer oder allogener Stammzelltransplantation ist eine unnötige Belastung für die Betroffenen, resümierte Dr. Stella. Er glaubt, dass die Ernährungsform möglicherweise das Mikrobiom beeinflusst und das für die Ergebnisse eine Rolle spielt.
Quelle:
Stella F et al. 64th ASH Annual Meeting; Abstract 169